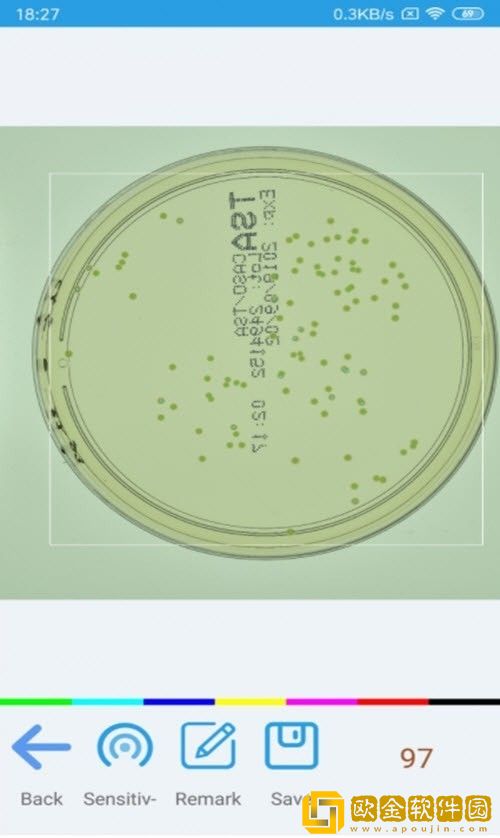
识别计数相机

识别计数相机中的工作效率也是很高的,为你带来了很多的模式,且这里的种类也是非常多样化的,使用起来也是很十分火爆的,为你提供了很多的魔兽,还能进行快速的识别哦,所有的识别功能都是比较好用的,识别计数相机中的是可以进行不同的快速AI的功能对比哦,还能进行不同的长度上的识别的!
识别计数相机app优势
识别计数相机可以通过摄像头对相似物体进行计数,可以手动添加或删除物体。
在几秒钟内对相似物体进行计数,并保存计数结果。是一款功能强大的识别技术软件。
使用简单方便,提高工作效率。给你真的超级多的,还有很多的选择哦!

识别计数相机app特色
识别计数相机多分类统计,可以一次性统计多种分类物品,并计算每种分类物品数量
提供区域圈选功能,更准确快速的进行识别,人工纠正功能,可以人工对结果进行纠正操作
为各位用户们提供了高精度的相机服务。软件是一款高科技的AI计算识别相机功能
识别计数相机app亮点
提供不断更新的模板库,用户可通过模板库选择符合自己要求的模板进行统计
识别计数相机有着不同的识别模式,大家可以进行不同的体验,经典的技术模式
对物体尺寸无要求,可以统计多种尺寸的物品,不会因为尺寸差别而错误统计

识别计数相机app优点
识别计数相机是一款好用的相机软件,识别功能非常的强大,你可以用它来拍照。
快速的为你清点图片中的物品,使用非常方便,需要的朋友可以下载。
对您想计数的东西进行拍照,标识其中一个物体,然后就能算出结果。
识别计数相机app特点
多分类细微差别统计,可以对两种非常相似的物品进行分类统计,如药品是否残次
对多种形态复杂物品统计准确,可统计具有多种形态物品,如人这种复杂物品也可进行精准统计
对图片杂物坑干扰性强,在复杂的图片中可以轻松识别目标物体,对其他杂物干扰有很强的过滤效果
识别计数相机小编点评
识别计数相机为你带来了很多的选择,各种物品上的分类统计都是比较容易的,来试试吧!